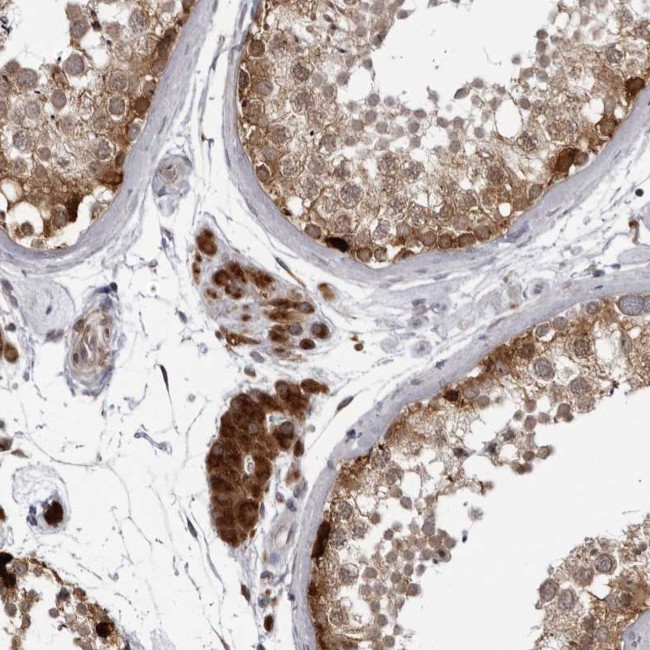
RTCA Antibody in Immunohistochemistry (Paraffin) (IHC (P))

Search
Invitrogen
RTCA Polyclonal Antibody
{{$productOrderCtrl.translations['antibody.pdp.commerceCard.promotion.promotions']}}
{{$productOrderCtrl.translations['antibody.pdp.commerceCard.promotion.viewpromo']}}
{{$productOrderCtrl.translations['antibody.pdp.commerceCard.promotion.promocode']}}: {{promo.promoCode}} {{promo.promoTitle}} {{promo.promoDescription}}. {{$productOrderCtrl.translations['antibody.pdp.commerceCard.promotion.learnmore']}}
产品信息
PA5-55777
种属反应
宿主/亚型
分类
类型
抗原
偶联物
形式
浓度
规格
纯化类型
保存液
内含物
保存条件
运输条件
RRID
产品详细信息
Immunogen sequence: PLRVQKIRAG RSTPGLRPQH LSGLEMIRDL CDGQLEGAEI GSTEITFTPE KIKGGIHTAD TKTAGSVCLL MQVSMPCV
Highest antigen sequence identity to the following orthologs: Mouse - 94%, Rat - 95%.
靶标信息
RTCD1 catalyzes the conversion of 3'-phosphate to a 2', 3'-cyclic phosphodiester at the end of RNA. The mechanism of action of the enzyme occurs in 3 steps: (A) adenylation of the enzyme by ATP; (B) the enzyme acts on RNA-N3'P to produce RNA-N3'PP5'A; (C) a non catalytic nucleophilic attack by the adjacent 2'hydroxyl on the phosphorus in the diester linkage to produce the cyclic end product. The biological role of this enzyme is unknown but it is likely to function in some aspects of cellular RNA processing. There are two named isoforms.
仅用于科研。不用于诊断过程。未经明确授权不得转售。
篇参考文献 (0)
生物信息学
蛋白别名: RNA 3'-terminal phosphate cyclase; RNA cyclase; RNA terminal phosphate cyclase domain 1; RNA terminal phosphate cyclase domain-containing protein 1; RTC domain-containing protein 1; unnamed protein product
基因别名: RPC; RPC1; RTC1; RTCA; RTCD1
UniProt ID: (Human) O00442
Entrez Gene ID: (Human) 8634